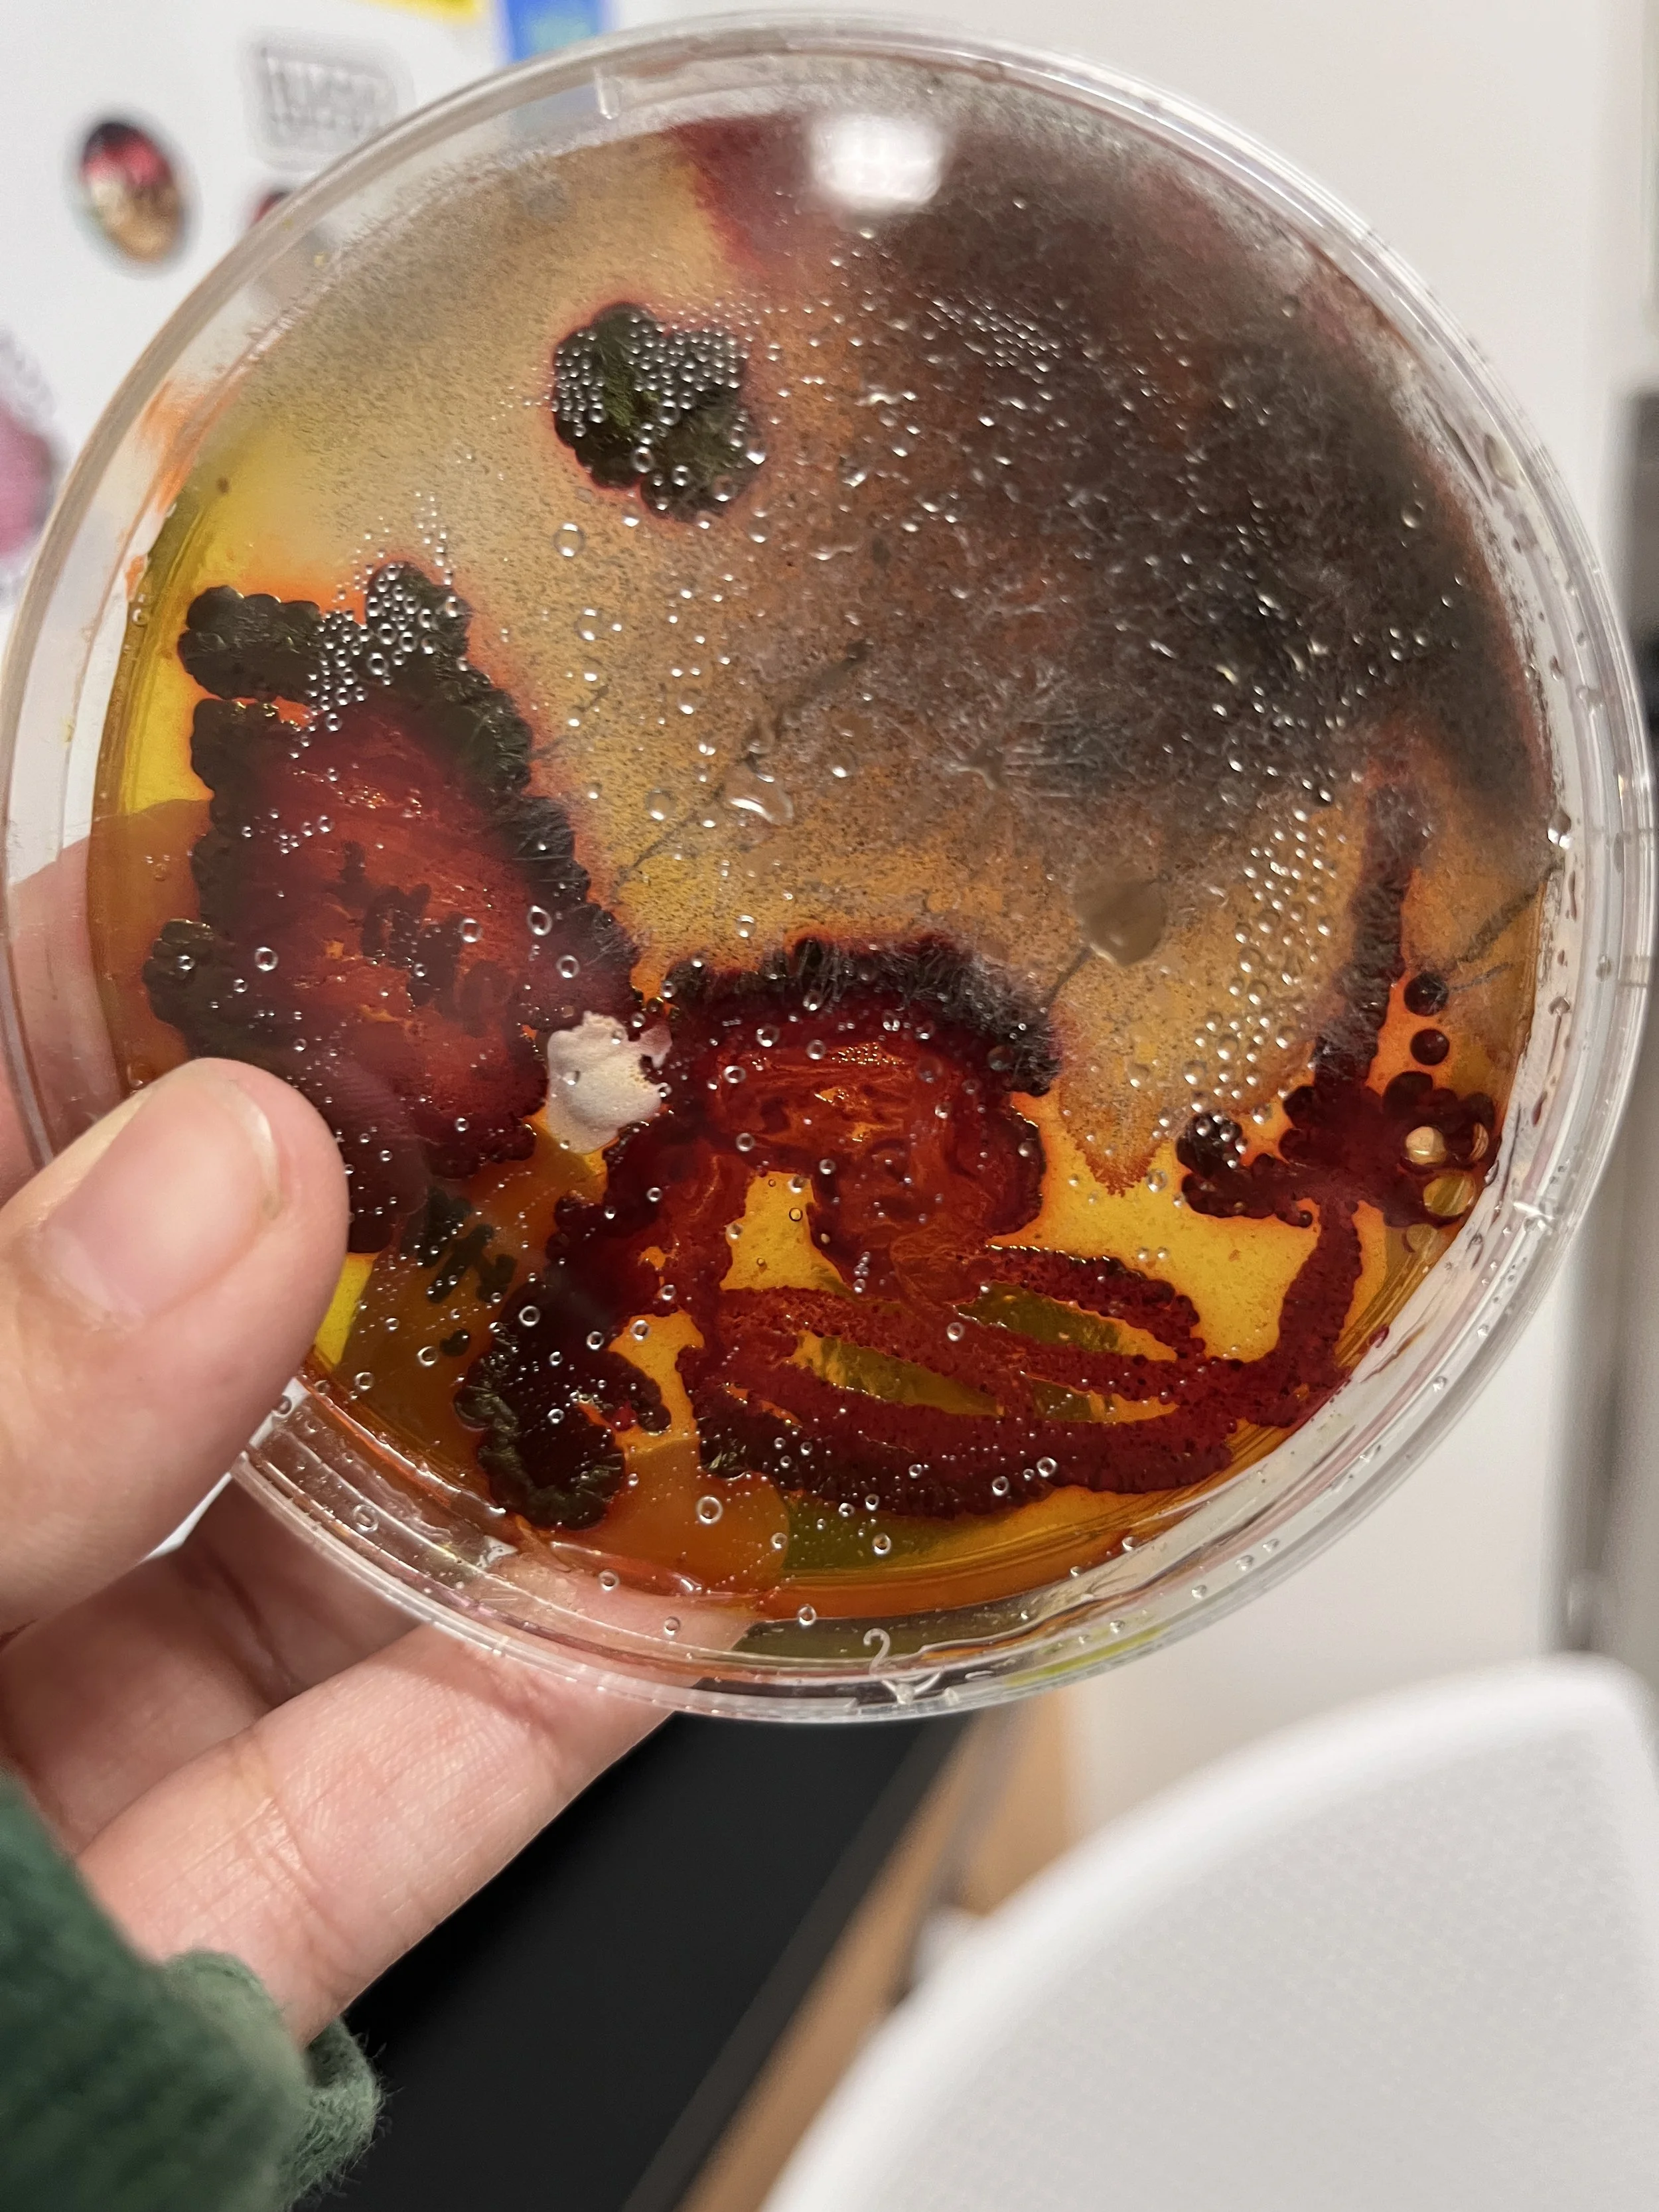

Ashley P.
WISRD Member
Statement of interest, Spring 2024: (from institute application): I want to continue the research project that I started with Anne Marie in my internship during this class. Our research consisted of growing fungi, bacteria, and molds and plating them to create art and observe how they interact. The end goal is to be able to create art that can be displayed at the end of the year and be able to fully explain and understand their coexistence and growth.
8.21.24

9.16.24
Bio Artistic Bacteria and Fungal Interraction
I’ve decided to start and try to find a method in which this bacterial, fungal art can be replicated with ease. Not to say that art is easy but a guide would help others if they’re interested.
First, the dye was mixed with agar to see what bacteria they would grow without being autoclaved

September: We have been concentrating on collecting skin samples from people of various ethnicities during September. Gingers were put into a different category as their skin has different sensitivities, making them a whole new category. We’ve noted the differences in each skin type we’ve taken and documented them in a google drive.
Week 1: Gathered skin and microbial culturing samples from the test subject’s foreheads and cheeks.
Week 2: Gathered skin and microbial culturing samples from the test subject’s foreheads and cheeks.
Week 3: After Gathering samples they were categorized and pictured for growth. We noticed specific bacterial coloring on certain slides and documented them.
Week 4: Once we observed enough growth on all the plates, they were disposed of in 10% bleach baths.





October
In October, I started to research the methods I wanted to use for the Bioart I wanted to make. I ordered Petri dishes, silicon, and a case to store the art. I planned methods of execution and finally got models to practice on.
Week 1:
Week2:
Week 3:
Week 4:






November
In November, I started trying to mold the faces I would need to grow on. I first experimented with 3D printing, getting a small mold of a man’s face and filling it with non-nutrient-containing agar. The face came out well-defined and perfect, so I decided to print the same mold on a bigger scale, and it came out great. I also used a silicon material to make a face mold of my friends Jess and Ava and used those to make more agar faces which came out with their likeness intact. I then accumulated bacteria and such by letting passerbyers touch all over the nutrient filled faces.
Week 1:
Week 2:
Week 3:




December
Week 1: Poster Work time
Week 2: Poster Work time
Week 3: ?






What do you do?
Take a minute to write an introduction that is short, sweet, and to the point. If you sell something, use this space to describe it in detail and tell us why we should make a purchase. Tap into your creativity. You’ve got this.




